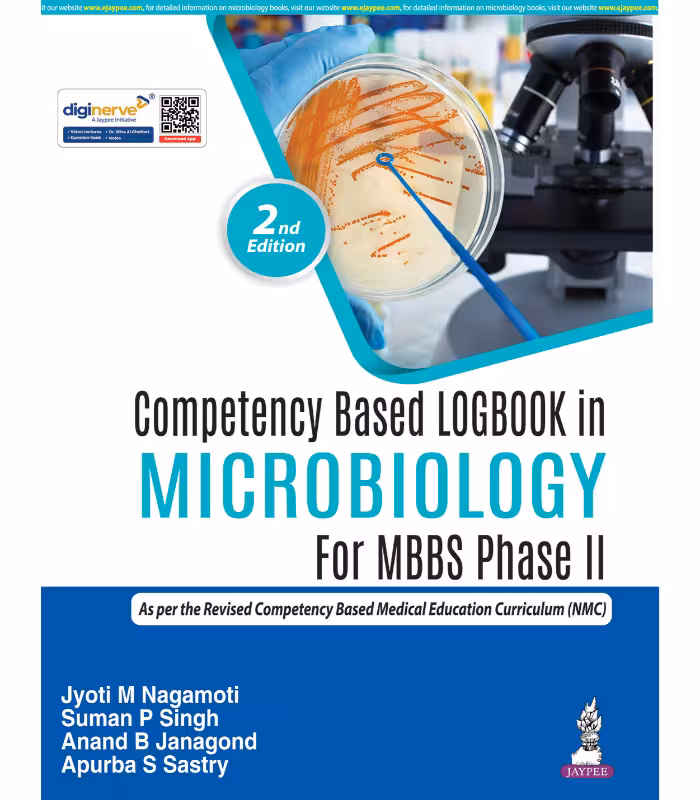

This logbook has been developed in alignment with the National Medical Commission Competency-Based Curriculum. It provides a comprehensive framework for recording the development of cognitive, psychomotor, and affective (behavioral) skills throughout the Microbiology course. Students can use this logbook to document their performance in day-to-day formative assessments as well as internal assessment (IA) tests. Suggested formats are included to facilitate the tabulation of unit-wise, block-wise, and final IA marks, which are required to be submitted to the University for eligibility to appear in the Summative Examination. This document is intended to support both students and faculty by enabling the systematic recording and monitoring of skill acquisition, and by promoting reflective practices that contribute to enhanced learning outcomes.
Competency Based Logbook In Microbiology For Mbbs Phase Iind
₹219.00
26% Off
Close
Price Summary
- ₹295.00
- ₹219.00
- 26%
- ₹219.00
- Overall you save ₹76.00 (26%) on this product
In Stock
Highlights:
- ISBN – 9789372026849
- Author – Jyoti M Nagamoti
- Edition – 2nd Edition
- Publisher – Jaypee Brothers Publisher
- Year – 2026
- Binding – Paperback
- Language – English
Ask a Question
Ask a Question
24 People viewing this product right now!
Additional information
| Weight | 1.6 kg |
|---|---|
| Dimensions | 8.25 × 10.5 × 2 cm |
| Edition | 2nd Edition |
| Author | Jyoti M Nagamoti |
| ISBN | 9789372026849 |
| Language | English |
| Year | 2026 |
| Binding | Paperback |
| Publisher | Jaypee Brothers Publisher |
| Pages | 56 |
Reviews (0)

There are no reviews yet.